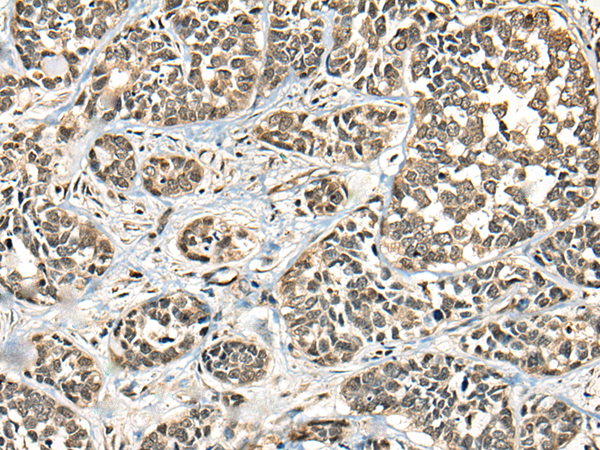
一抗

中文名稱 : 兔抗PIAS3多克隆抗體
英文名稱 : Anti-PIAS3 rabbit polyclonal antibody
別 名 : ZMIZ5
儲 存 : 冷凍(-20℃)
抗 原 : PIAS3
宿 主 : Rabbit
反應(yīng)種屬 : Human, Mouse, Rat
標 記 物 : Unconjugate
相關(guān)類別 : 一抗
克隆類型 : rabbit polyclonal
技術(shù)規(guī)格
|
Background: |
This gene encodes a member of the PIAS [protein inhibitor of activated STAT (signal transducer and activator of transcription)] family of transcriptional modulators. The protein functions as a SUMO (small ubiquitin-like modifier)-E3 ligase which catalyzes the covalent attachment of a SUMO protein to specific target substrates. It directly binds to several transcription factors and either blocks or enhances their activity. Alternatively spliced transcript variants of this gene have been identified, but the full-length nature of some of these variants has not been determined. |
|
Applications: |
ELISA, IHC |
|
Name of antibody: |
PIAS3 |
|
Immunogen: |
Synthetic peptide of human PIAS3 |
|
Full name: |
protein inhibitor of activated STAT 3 |
|
Synonyms: |
ZMIZ5 |
|
SwissProt: |
Q9Y6X2 |
|
ELISA Recommended dilution: |
5000-10000 |
|
IHC positive control: |
Human thyroid cancer and human ovarian cancer |
|
IHC Recommend dilution: |
25-100 |


 購物車
購物車 幫助
幫助
 021-54845833/15800441009
021-54845833/15800441009